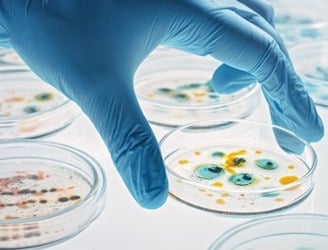

Clinical Pathology
Clinical chemistry (also known as chemical pathology) extends across most medical specialties and involves the biochemical investigation of bodily fluids (blood – whole blood, serum or plasma; urine; cerebrospinal fluid; and other fluids such as effusions, seminal fluid, sweat, and amniotic fluid...


Laboratory tests measuring hormone levels are important in diagnosing endocrine (hormonal) disorders. The endocrine system is complex and results need to be interpreted with clinical information. Hormone levels can fluctuate e.g. level of cortisol is affected by time of day sample is taken, level...


Laboratory haematology involves testing for disorders of the blood and bone marrow. Automated analysers count the number of blood cells; in particular red blood cells, white blood cells and platelets

Microbiology plays a key role in diagnosing and treating infectious diseases. Relevant samples from tissue, body fluids (blood, urine, faeces, CSF, abscesses, ascites, pleural fluid) are analysed to identify micro-organisms; bacteria, fungi, parasites, viruses.


The immune system produces antibodies in response to infection, inflammation and in autoimmune diseases. The presence of antibodies to specific organisms (viral/bacterial) can indicate current and/or previous infection or vaccination. In autoimmune conditions the body produces ‘an immune reaction...


Genetic testing identifies changes in genes, chromosomes or proteins. Molecular diagnostics involves analysing DNA or RNA from cells. The field is rapidly evolving with new highly complex tests and technologies being integrated into clinical practice. The goal is to achieve precision medicine.
I experienced a remarkable transformation in my health through natural healing. The treatments offered here truly minimize the need for conventional drugs. Highly recommend!
John Doe
★★★★★




